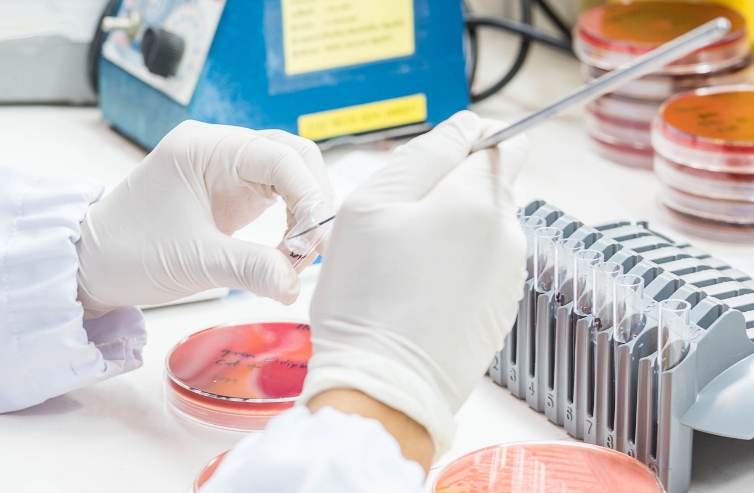

Infectious Disease
Systems-Based Testing for Timely, Reliable Results
TriCore offers comprehensive infectious disease testing designed to support healthcare providers with accurate and timely diagnostics. Our advanced testing capabilities span a wide range of infectious diseases, helping clinicians make informed decisions for patient care. Through our expertise in molecular diagnostics, serology, and microbiology, we deliver precise results that aid in diagnosis, treatment, and disease management.
By providing local testing, rapid turnaround times, and direct access to our specialists, we provide healthcare providers with prompt, high-quality results. Specimens are collected and analyzed right here in New Mexico, ensuring reliability and efficiency throughout the entire process.
Already a provider working with our team? Access resources:
TriCore’s Infectious Disease Testing Offers a Systems-Based Diagnostic Approach
Respiratory Infections: Bacterial, Viral, and Fungal/AFB
Traditional culture for various upper and lower respiratory sources for bacteria, fungus and AFB as well as PCR for a wide variety of respiratory infections. Specific testing for patients with cystic fibrosis is also available.
Gastrointestinal Infections—Bacterial, Viral, and Parasite
Testing for gastrointestinal infections is offered as panel testing for bacteria, viruses or parasites. For immunocompromised patients or patients with travel outside of the country, microscopic detection of ova and parasites is also available.
Genitourinary Tract Infection
Urine culture is available to detect UTls. Detection of sexually transmitted infections from genital or extragenital is available.
Systemic and Invasive Infections—Bacterial, Viral, and Meningitis
Comprehensive testing includes culture for bacteria, fungus and AFB. PCR can be performed for variety of pathogens and sources. Rapid PCR testing is available for meningitis/encephalitis.
Skin and Soft Tissue Infections—Bacterial and Viral
Detection of bacteria, fungus or AFB can be performed from swabs and tissues. PCR is available for detection of viral infections such as HSV 1&2 and VZV.
Infection Control and Prevention
Detection of organisms such as MRSA, C. difficile and Candida auris. for diagnostic and infection control purposes is performed using the most up-to-date detection protocols.
Meet Our Team
Karissa Culbreath, PhD, D(ABMM)
is board certified by the American Board of Medical Microbiology. Dr. Culbreath earned her PhD in Microbiology and Immunology from Vanderbilt University and completed a postdoctoral fellowship in Medical and Public Health Microbiology at the University of North Carolina at Chapel Hill. She currently serves as Section Chief and Medical Director of Infectious Disease at TriCore in Albuquerque, New Mexico. Dr. Culbreath is also volunteer faculty in the Department of Pathology at the University of New Mexico School of Medicine. Her areas of expertise include laboratory innovation, analytics and the application of diagnostic testing to increase access in underserved communities
Contact Dr. Culbreath
Karissa.Culbreath@TriCore.org
Gabriela Uribe, PhD, (ABMM)
is board certified by the American Board of Medical Microbiology. Dr. Uribe earned her PhD in Cell Biology from the University of Texas Medical Branch in Galveston, Texas and completed a postdoctoral fellowship in Medical and Public Health Laboratory Microbiology at the University of Washington. Currently serving as the Medical Director of Molecular and Rapid Diagnostic Infectious Disease testing at TriCore, Dr. Uribe also volunteers as a Clinical Assistant Professor in the Department of Pathology at the University of New Mexico School of Medicine. Dr. Uribe has special interests in diagnostic molecular microbiology and the application of molecular testing in public health epidemiology.
Contact Dr. Uribe
Gabriela.Uribe@TriCore.org
John Fissel, PhD, D(ABMM)
is board certified by the American Board of Medical Microbiology. Dr. Fissel earned his PhD in Pathobiology from the Johns Hopkins University School of Medicine and completed a postdoctoral fellowship in Medical and Public Health Laboratory Microbiology at Children's Hospital Los Angeles. He currently serves as the Medical Director of Microbiology at TriCore in Albuquerque, New Mexico and as a volunteer Clinical Assistant Professor in the Department of Pathology at the University of New Mexico School of Medicine. Dr. Fissel has special interests in antimicrobial susceptibility testing, laboratory testing stewardship, and next-generation sequencing.
Contact Dr. Fissel
John.Fissel@TriCore.org
New Mexico Respiratory Infections Dashboards
The wellness of patients and their families is TriCore's utmost concern, and we keep a constant finger on our community’s health. Through our extensive and diverse set of laboratory data, we are able to provide patients, providers, and the public with a clearer, current picture of infectious disease trends in our state. Click to see current trends in influenza, COVID-19, Rhinovirus, and more.
Work With Us
At TriCore, our goal is to help you reach a diagnosis quickly and cost effectively. From choosing the right test to helping with results interpretation, our pathologists and scientists work closely with you to ensure that you receive the full benefit from every diagnostic test you order.